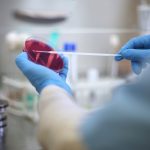

Mathematics News Archive

Faculty of Science
Witness the spark in science when students compete for $3,000 cash prize!
March 25, 2024 —
Science Spark 3K Pitch Competition 2024 presented by the Bioscience Association Manitoba (BAM) is happening on April 8th, 1:00 p.m. at Marshall McLuhan Hall as 9 teams of science students pitch their innovative ideas and compete for a chance to win a $3,000 cash prize! The event is free but registration is required.

Faculty of Science
Volunteer for Science Rendezvous 2024
March 10, 2024 —
Volunteer for Science Rendezvous 2024 because we can't do this without you and this is the event you're going to remember you volunteered for, made friendships and connections with your peers, faculty and staff, and got Experience Record once you spent more than 10 hours volunteering.

Research and International
UM researchers recognized with Rh Awards
May 31, 2023 —
Eight UM faculty members will receive Rh Awards, recognizing excellence in research, scholarly work and creative activities.

Research and International
Meet Mikaël Slevinsky, 2022 Rh Award Winner in the Natural Sciences category
May 26, 2023 —
Mikaël Slevinsky is the 2022 recipient of the Terry G. Falconer Memorial Rh Institute Foundation Emerging Researcher Award in the

Faculty of Science
How Epidemics End
January 20, 2023 —
How do societies know when an epidemic is over and normal life can resume? What are the criteria and markers of an epidemic’s end, and who has the insight, authority, and credibility to decipher these signs? Join Dr. Erica Charters, professor of the global history of medicine at the University of Oxford for an insightful conversation on how war, disease, and state formation intersect. Erica Charters currently leads a multidisciplinary project on How Epidemics End.

Faculty of Science
Discover Your Future in Science: Upcoming Information Sessions
January 13, 2023 —
Attention all students: Do you have passion for science but you aren’t sure what you can do with a science degree? If so, consider attending The Discover Your Future in Science series.

Elite researchers recognized with Rh Awards
May 27, 2022 —
Eight UM faculty members to receive Rh Awards, recognizing excellence in research, scholarly work and creative activities

Extended Education
Imagine what AI and Machine Learning can do for you
May 17, 2022 —
“I see it as an important new kind of literacy. If you don’t understand AI and Machine Learning, others have an advantage over you. You don’t need to program but you need to understand.” - Cunyet Akcora

Faculty of Science
Cheer on the Faculty of Science 3MT 2021 Competitors
August 6, 2021 —
On August 10 and 11, 2021, students will be challenged to showcase their research to a general audience in a three-minute or less in a 3MT competition. Part of the Faculty of Science, Student Undergraduate Summer Research Experience Program.
Faculty of Science
NSERC 2021 research grant recipients announced
July 13, 2021 —
From the Subarctic to Subatomic Physics, several big ideas from scientists at the Faculty of Science have received funding from the Natural Sciences and Engineering Research Council of Canada (NSERC) Discovery Grants Program






